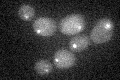
YKL089W
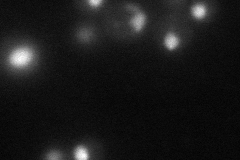
YKL089W
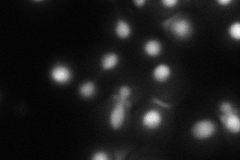
YKL089W
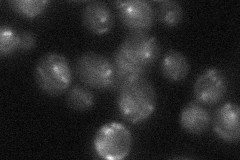
YKL089W

View description
Kinetochore protein with homology to human CENP-C, required for structural integrity of the spindle during anaphase spindle elongation, interacts with histones H2A, H2B, and H4, phosphorylated by Ipl1p
Localization:
Intensity:
Fold change:
Significance:
-
C’ GFP library in SD
punctate18.04 -
N' NOP1pr-GFP in SD
nucleus40.5823 -
N' TEF2pr-mCherry in SD
nucleus49.5972 -
N' NATIVEpr-GFP in SD
below threshold22.3866 -
N' TEF2pr-VC and Cyto-VN in SD

#N/A0 -
C’ GFP library in SD+DTT

punctate19.431.07No -
C’ GFP library in SD+H2O2

punctate17.950.99No -
C’ GFP library in Starvation Media

punctate17.420.96No -
C’ GFP library on the background of Pup2-DaMP

punctate -
C’ GFP library on the background of CCT mutant

punctate19.37011.07362No
